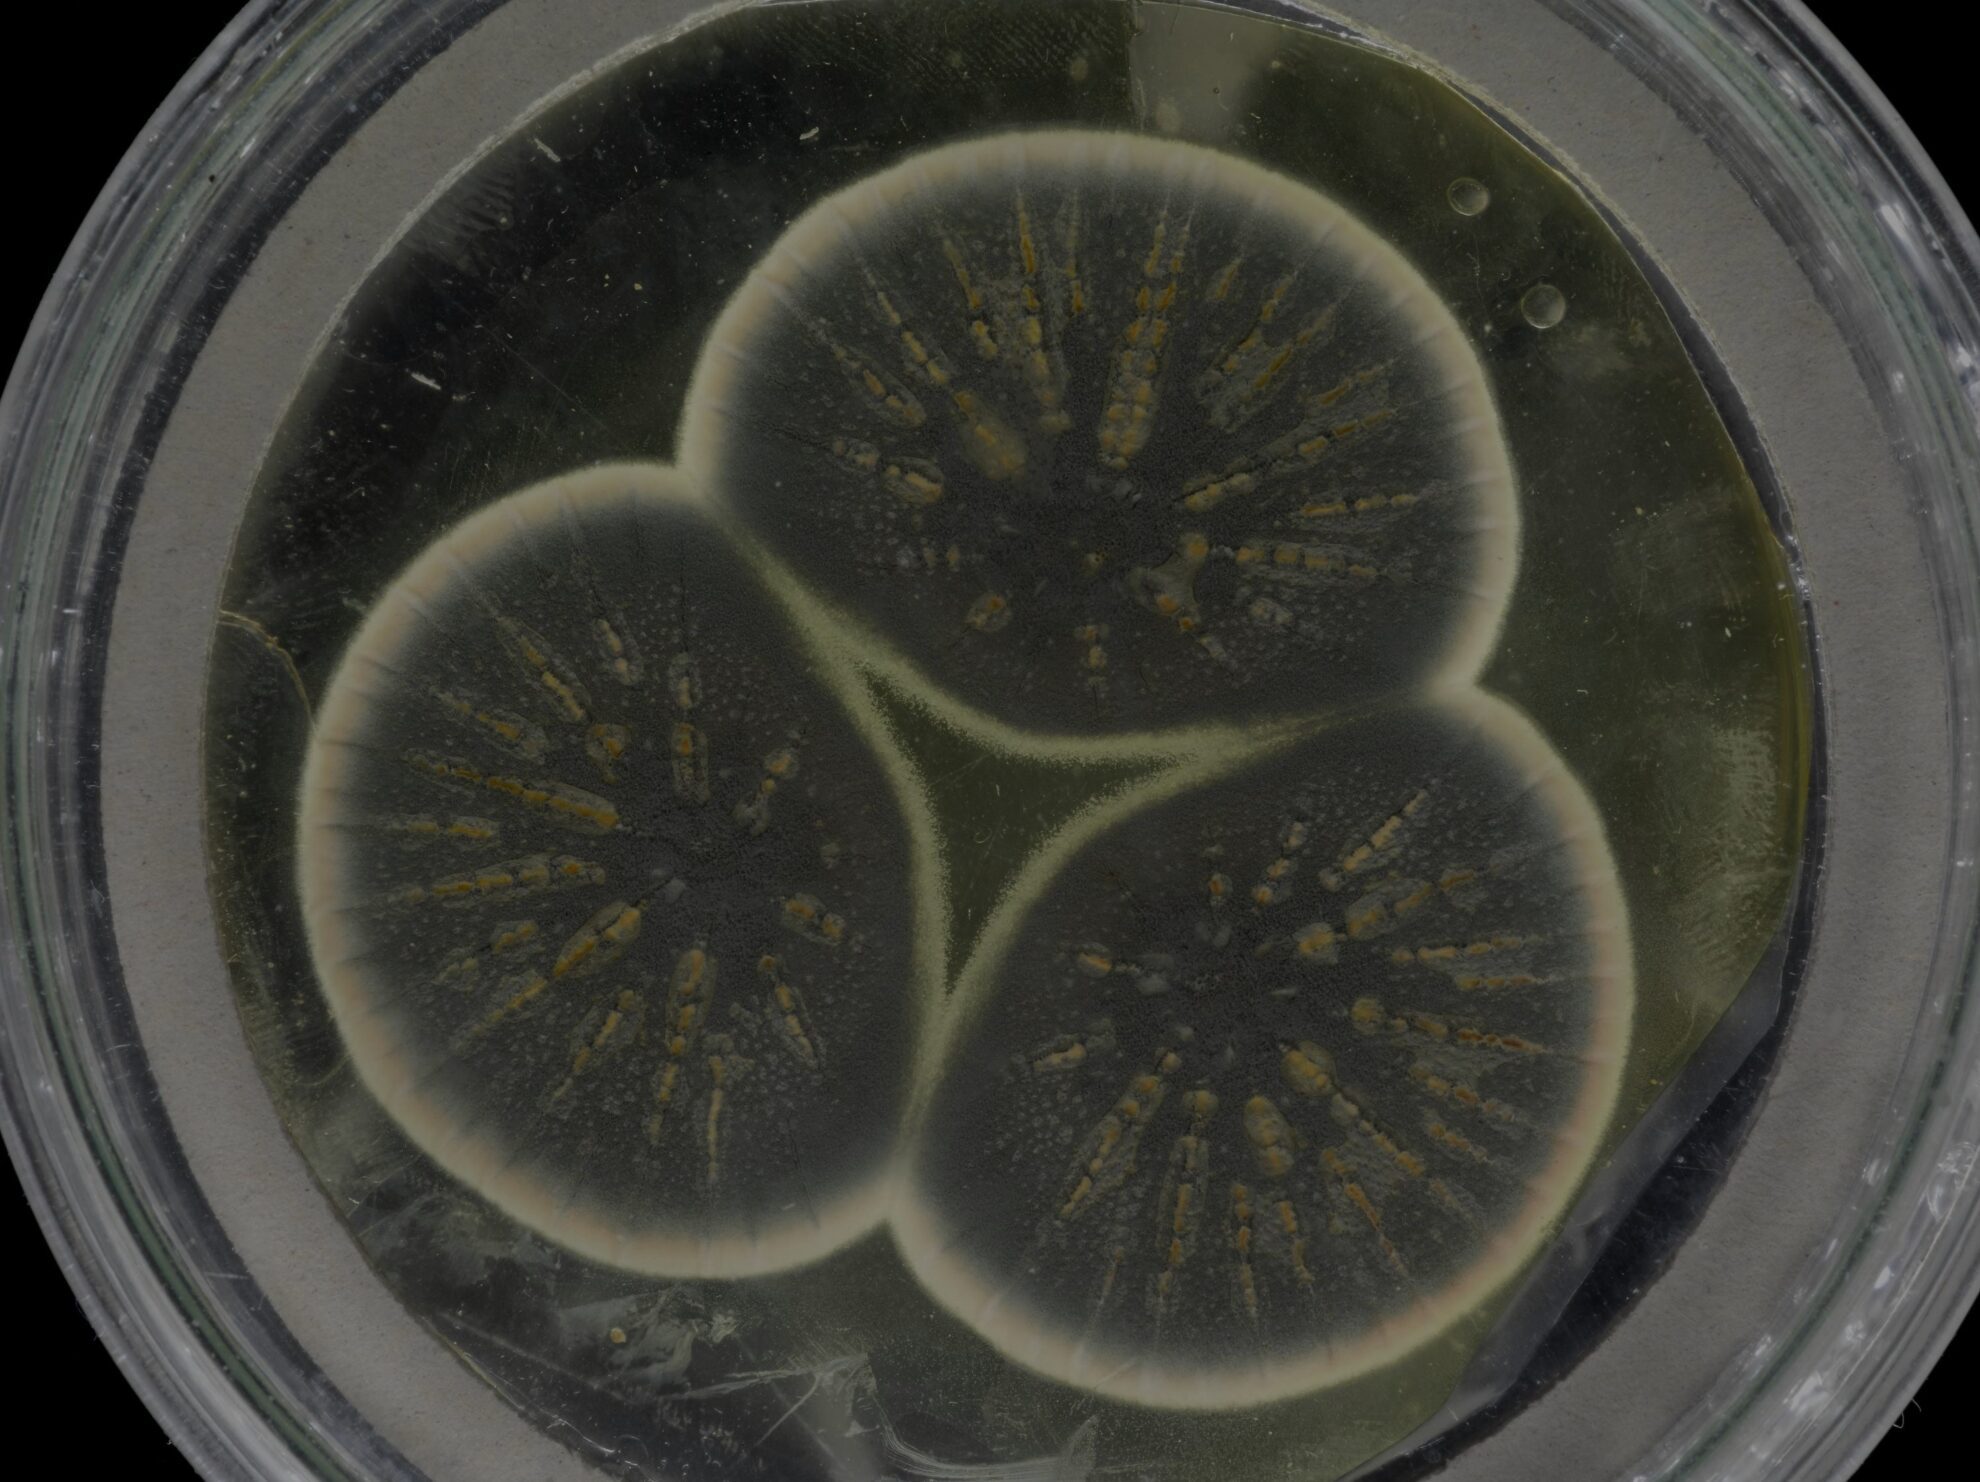
Whole catalogue

CABI manages a collection of over 30,000 living strains from 142 nations (90% unique to CABI). It is one of the world’s largest living collections of fungi and bacteria, holding the UK’s National Collection of Fungus Cultures, which most notably includes Fleming’s penicillin-producing isolate.
Our collection allows customers to carry out taxonomic and molecular studies, assays, testing, research and teaching. Terms can also be arranged for cultures used in commercial products.
Browse our online catalogue and place an order (Please note, you will be redirected to a JotForm).
Organisms available
Filamentous fungi and yeasts, plant pathogenic bacteria, biocontrol agents, production strains for enzymes, metabolites, active biomolecules and novel products, authenticated reference, type and test strains for businesses and research establishments.
Our catalogues are available by clicking on the images below. They include our whole public catalogue and subsets, which we have selected for their potential to address key research areas.
We also hold strains that are not in our catalogues but could provide solutions to global problems, such as ones that are not named to species level. Contact us using the details below if you are interested in working with us on these.
Quality assurance
The culture collection is a member of the United Kingdom Biological Resource Centre Network (UKBRCN), is a UNESCO Microbial Resource Centre (MIRCEN), and an International Depository Authority (IDA) within the Budapest Treaty (1977).
Our fungal culture collection operates:
- To the World Federation for Culture Collection (WFCC) guidelines for culture collections
- In the spirit of the Convention on Biological Diversity and full compliance with Nagoya Protocol
Deposit
Precious cultures can also be stored as freeze-dried and under liquid nitrogen (gold standard) at CABI. We offer:
- Safe deposit: Confidential, off-site, long-term storage of valuable live cultures
- Patent deposit: CABI is recognized as an International Depository Authority for patent cultures under the Budapest Treaty
Contact us
For further information about CABI's culture collection, it's microorganism supply and deposit services, please get in touch.
Email: cultures@cabi.org
Telephone: +44 (0) 1491 829080

National Reference Collection
Established in partnership with CABI and Fera, the UK Agri-Tech Centre (formerly Crop Health and Protection (CHAP)) launched a National Reference Collection in 2021. Located at CABI, this facility contains a collection of plant pathogenic fungi and bacteria, entomopathogens, and food spoilage organisms of importance to UK agriculture. The facility identifies crop pathogens, monitors their spread and discovers potential new biopesticides. The National Reference Collection can be browsed here.